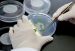
Чашки Петри, 100×40 мм, нестерильные, SPL

Чашки Петри, 100×40 мм, нестерильные, SPL (В НАЛИЧИИ)
Чашки Петри, 100×40 мм, нестерильные, SPL
Предназначены для микробиологических работ и работ с культурами тканей растений.
- Конструкция обеспечивает отличную циркуляцию воздуха;
- Плоские и ровные;
- Стабильно штабелируются;
- Снижают риск контаминации;
- Автоклавируемы;
- Соответствуют ISO 9001:2015 (K-QA-Q031478).
Данный продукт предназначен для исследовательских целей.
- Стерильность: -
- Крышка: Есть
- Диаметр (мм): 100
- Высота (мм): 40
- Материал: Полипропилен (ПП)
- Упаковка: 10 шт.
- Транспортная коробка: 200 шт.
- Документы: Для исследовательских целей